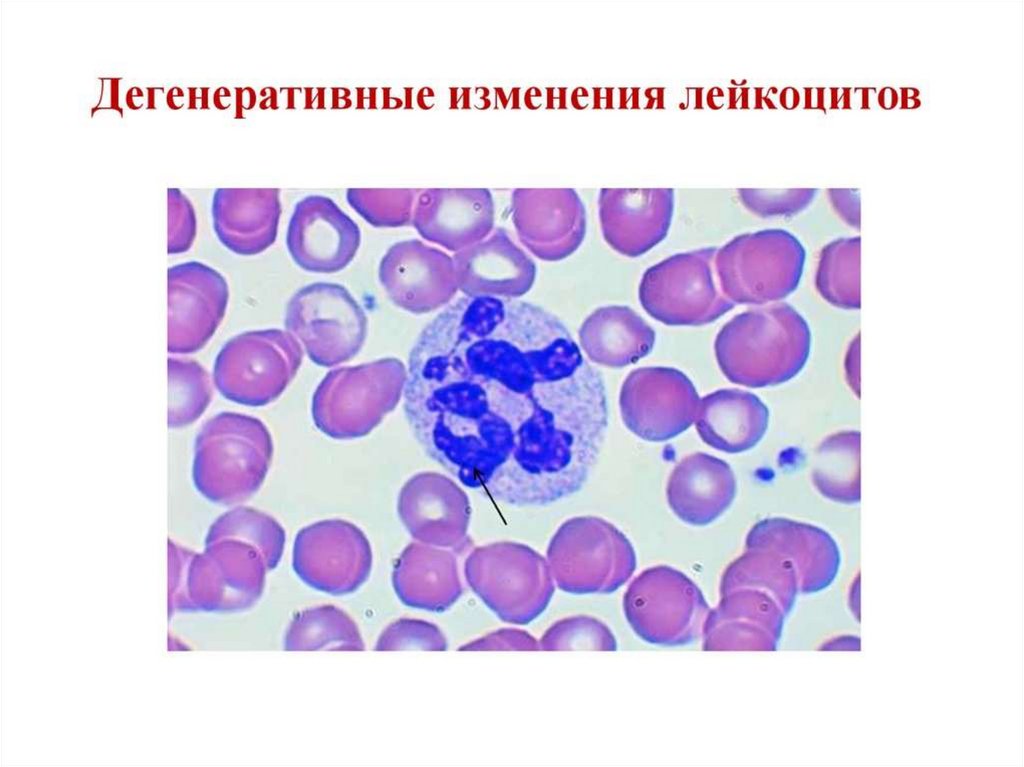
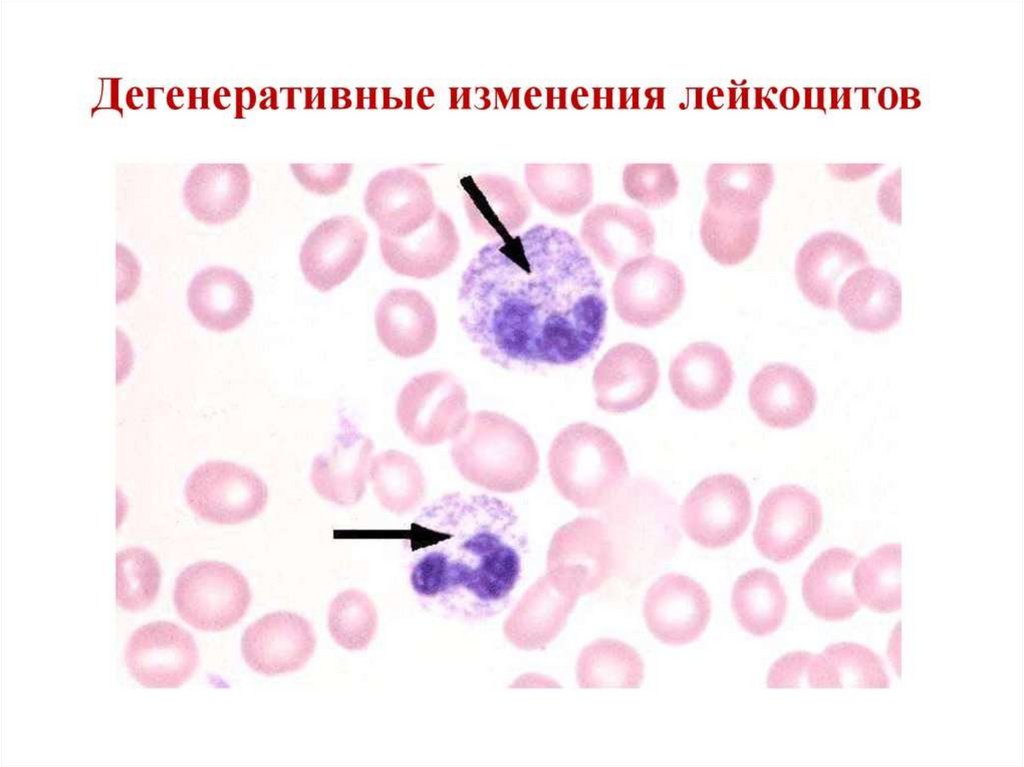
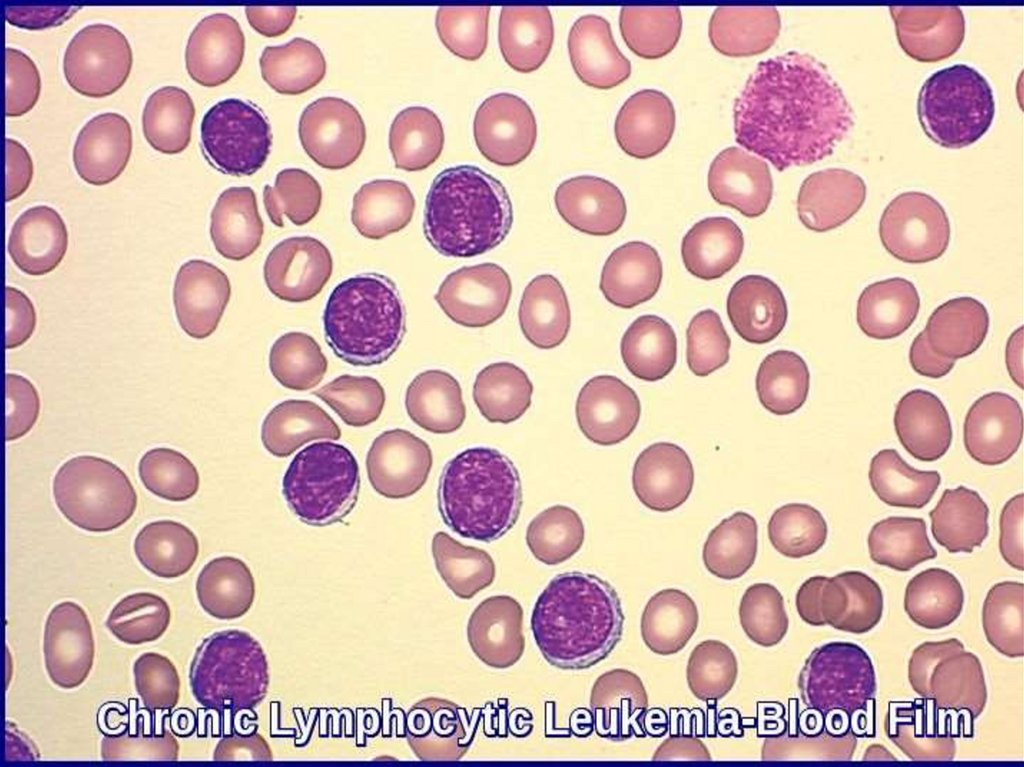

Similar presentations:
Патология «белой» крови
1. Патология «белой» крови
Подготовила лекцию к.м.н., доценткафедры патофизиологии УГМУ
г. Екатеринбург 2024г.
2. Патология лейкоцитов: 1. Лейкоцитозы, 2. Лейкопении, 3. Лейкемоидные реакции и 4.Гемобластозы
3.
4.
5.
6. Регуляция лейкопоэза
1.2.
3.
4.
5.
6.
Колониестимулирующий фактор (КСФ)
Лейкопоэтины:
а)лейкоцитозиндуцирующий фактор (ЛИФ)
б)фактор активирующий лейкопоэз (ФАЛ)
Интерлейкины (ИЛ 2-7)
Продукты разрушения лейкоцитов
(воспаление)
Факторы лейкопении (ингибиторы)
Неспецифические факторы регуляции
лейкопоэза
7.
8.
9.
10. Физиологическая норма лейкоцитов. Лейкоцитарная формула.
Нейтрофилы палочкоядерные (1-6%)Нейтрофилы сегментоядерные (45-72%)
11.
Эозинофилы (0-5%)Базофилы (0,5-1%)
12.
Моноциты (2-10%)Лимфоциты (20-40%)
13. Ядерный индекс
нейтрИЯС= Метамиелоциты+палочкоядерные
Сегментоядерные нейтрофилы
ИЯС=0,05-0,1
14.
15.
16.
17.
18.
19.
20.
21.
22. Лейкоцитозы
I. Лейкоцитозы при физиологических состояниях1. Лейкоцитозы новорожденных
2. Лейкоцитозы беременных
3. Миогенный лейкоцитоз
4. Пищеварительный лейкоцитоз
II. Реактивные лейкоцитозы, развивающиеся при
действии физических, химических и
биологических факторов
23.
24.
25.
26.
27. Эозинофильный лейкоцитоз
1. Аллергические болезни – бронхиальная астма,поллинозы, крапивница, лекарственная
аллергия
2. Гельминтозы
3. Кожные болезни – псориаз, экзема,
герпетиформный дерматит
4. Злокачественные опухоли
28.
29.
30.
31. Причины моноцитоза
1. Инфекционный вирусный мононуклеоз2. Инфекционный эндокардит
3. Малярия
4. Неспецифический язвенный колит
5. Ревматоидный артрит
6. Эпидемический паротит
32.
33.
34.
35.
36. Лейкемоидные реакции
Это патологический лейкоцитознеопухолевой природы, сопровождающийся
появлением в крови клетокпредшественников – бластов, промиелоцитов
и миелоцитов. Это симптоматическое
состояние, так как их развитие обусловлено
большей частью инфекционными и
токсическими факторами.
37. Лейкемоидная реакция
38.
39.
40.
41.
42.
43.
44.
45. Лейкопении
1.Общие нарушения гемопоэза (лейкопоэза):а)анаплазия (патология клеток образующих КСФ)
б)метаплазия (опухоль)
в)токсическое воздействие (химические, лекарственные
вещества)
г)физические факторы (радиация, низкая температура)
д) инфекции (ВИЧ, вирусные гепатиты, брюшной тиф,
малярия)
2. Наследственные факторы: (б. Костмана, семейная
нейтропения, циклическая нейтропения)
3. Дефицитные лейкопении (железо-, В12 и
фолиеводефицитные анемии)
4. Аутоиммунные заболевания
46.
47.
48. Нейтропения
49.
50.
51.
52.
53.
54.
ГемобластозыГемобластозы — опухолевые
заболевания кроветворной и
лимфатической ткани.
Гемобластозы подразделяют на
системные заболевания —
лейкозы, а также регионарные
— лимфомы.
55.
56.
57. Гемобластозы
Опухолевые новообразования,возникающие из клеток кроветворной
ткани.
1. Лейкозы – системные опухолевые
заболевания, диффузно поражающие
кроветворную ткань с первичной
локализацией в костном мозге
2. Гематосаркомы – первичная
внекостомозговая локализация – миело,
лимфо и эритробластные саркомы,
лимфомы, лимфогранулематоз
58.
59.
60. Этиология
I. Теория физического канцерогенеза (лейкозрадиологов и рентгенологов)
II. Теория химического канцерогенеза (бензол,
ПАУ, цитостатики и др.)
III. Теория вирусного канцерогенеза (вирус
Эпштейна-Барра, вирус мышей, обезьян)
61. Этиология
IV. Мутационно-генетическая теория(нарушения состава и структуры хромосомного
аппарата наследственного и приобретенного генеза).
А) Генетическая предрасположенность:
• Синдром Дауна
• Синдром Клайнфельтера
Б) Нестабильность хромосом гемопоэтических клеток
В) Снижение активности ферментов реактивного
синтеза нуклеиновых кислот
Г) Недостаточная резистентность хромосом к
действию различных факторов.
62.
63.
64.
65.
66.
67.
68.
69.
70. Патогенез
Различают 3 стадии:1 звено – стадия инициации (трансформации) –
происходит мутация гемопоэтических клеток и их
трансформация в опухолевые клетки.
2 звено – стадия промоции – происходит
пролиферация и безудержный рост опухолевых
клеток, повторные мутации, уничтожение наиболее
чувствительных и размножение наиболее
автономных клонов.
3 звено – стадия инфильтрации (прогрессии) –
переход лейкоза в поликлоновую форму, нарастание
малигнизации.
71. Патогенез
Правило опухолевой прогрессии (А.И. Воробьев. 1965г).1. Переход опухоли в поликлоновую форму
2. Утрата способности к созреванию – анаплазия,
безграничный рост - гиперплазия
3. Угнетение всех ростков кроветворения
4. Формирование бластного криза
5. Развитие метастазирования – формируются
экстрамедулярные очаги кровотворения
6. Прогрессирующее повышение лейкоцитов в
крови (до 50 г/л и более)
7. Утрата ферментативной специфичности
8. Уход из-под контроля цитостатиков
72.
73.
74.
75. Классификация
Среди множества различных классификаций лейкозовнаибольшее признание получила классификация франкоамерикано-британской группы (FAB, 1976), на основе
которой выделяют миелобластные и лимфобластные
формы острого лейкоза. В свою очередь в группе острых
миелобластных лейкозов выделяют 8 их вариантов, а в
группе острых лимфобластных лейкозов – 3 типа.
Хронические лейкозы подразделяются на лейкозы
миелоцитарного и лимфоцитарного происхождения .
76.
77.
78. Диагностика
1. Общий анализ крови.2. Анализ пунктата костного мозга (миелограмма) —
является обязательным в постановке диагноза.
3.Трепанобиопсия подвздошной кости производится,
когда цитологический анализ миелограммы не
позволяет с уверенностью поставить диагноз лейкоза.
79.
4. Цитохимическое исследование препаратовстернального пунктата - имеет большое значение
для определения различных вариантов острого
лейкоза, что важно, прежде всего, для выбора
метода лечения.
При острых лимфобластных лейкозах
определяется положительная реакция на гликоген,
отрицательная на липиды, пероксидазу,
хлорацетатэстеразу.
При хроническом миелолейкозе положительная на
миелопероксидазу, липиды, хлорацетатэстеразу.
80.
5. Иммунофенотипирование бластов спомощью моноклональных антител
определяет наличие или отсутствие кластеров
дифференцировки бласных клеток (CD маркеры) позволяет разработать
соответствующую программу терапии.
6. Цитогенетические методы исследования
позволяют дифференцировать различные
варианты лейкоза.
81.
82.
83. Острые лейкозы
Это результат накопления ранних(I-IVкласс) предшественников миелопоэза и
лимфопоэза в костном мозге, крови и других
тканях
84. Острый миелобластный лейкоз
Мазок костного мозга85.
Острый миелобластный лейкозМазок крови
86.
87. Хромосомные аномалии при острых лейкозах
88.
89.
90. Хронические лейкозы
Опухоли, возникающие в результате мутацииодной из ранних клеток миелопоэза,
дифференцирующихся до зрелых клеток (VVI класс), сохраняющих способность к
пролиферации
91. Хронический миелолейкоз
Мазок крови92.
93. Филадельфийская хромосома
94.
95.
96.
97.
98.
99.
100. Принципы терапии
1.2.
3.
4.
5.
Точное определение типа лейкоза
Интенсивная терапия на всех этапах
лечения
Разработка комбинированной схемы
противолейкозных препаратов
Снижение побочных эффектов
цитостатиков
Симптоматическая терапия

medicine
medicine








